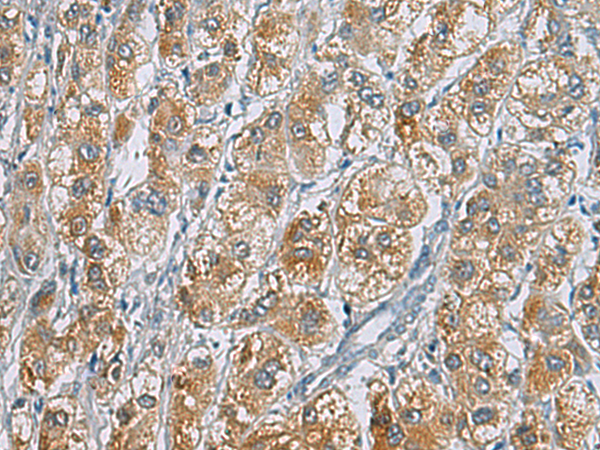

中文名稱:兔抗CENPE多克隆抗體
英文名稱: Anti-CENPE rabbit polyclonal antibody
別 名: KIF10; CENP-E; PPP1R61
相關類別: 一抗
儲 存: 冷凍(-20℃)
宿 主: Rabbit
抗 原: CENPE
反應種屬: Human, Mouse
標 記 物: Unconjugate
技術規格
|
Background: |
Centrosome-associated protein E (CENPE) is a kinesin-like motor protein that accumulates in the G2 phase of the cell cycle. Unlike other centrosome-associated proteins, it is not present during interphase and first appears at the centromere region of chromosomes during prometaphase. This protein is required for stable spindle microtubule capture at kinetochores which is a necessary step in chromosome alignment during prometaphase. This protein also couples chromosome position to microtubule depolymerizing activity. Alternative splicing results in multiple transcript variants encoding distinct protein isoforms. |
|
Applications: |
ELISA, WB, IHC |
|
Name of antibody: |
CENPE |
|
Immunogen: |
Synthetic peptide of human CENPE |
|
Full name: |
centromere protein E |
|
Synonyms: |
KIF10; CENP-E; MCPH13; PPP1R61 |
|
SwissProt: |
Q02224 |
|
ELISA Recommended dilution: |
5000-10000 |
|
IHC positive control: |
Human liver cancer |
|
IHC Recommend dilution: |
50-100 |
|
WB Predicted band size: |
316 kDa |
|
WB Positive control: |
Human vermiform appendix tissue lysate |
|
WB Recommended dilution: |
200-1000 |

購物車
幫助
021-54845833/15800441009
